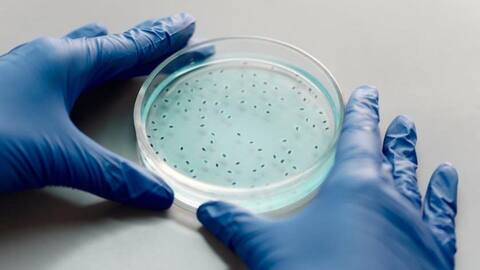

Kekuatan Sel Bahan Bakar Mikroba dalam Energi Hijau Masa Depan
Apa ceritanya
Sel bahan bakar mikroba (MFC) adalah teknologi inovatif yang memanfaatkan mikroorganisme untuk menghasilkan listrik. Teknologi ini menawarkan solusi berkelanjutan untuk kebutuhan energi masa depan dengan memanfaatkan limbah organik sebagai sumber energi. MFC bekerja dengan cara mengubah bahan organik menjadi listrik melalui proses biologis, menjadikannya pilihan yang ramah lingkungan dan efisien.
Konsep Dasar
Prinsip Kerja Sel Bahan Bakar Mikroba
MFC bekerja berdasarkan prinsip bahwa mikroorganisme dapat mengoksidasi bahan organik dan melepaskan elektron. Elektron ini kemudian ditangkap oleh elektroda, menghasilkan arus listrik. Proses ini tidak hanya menghasilkan energi tetapi juga membantu dalam pengolahan limbah, menjadikannya solusi dua-dalam-satu untuk masalah lingkungan dan energi.
Manfaat Lingkungan
Manfaat Lingkungan dari MFC
Salah satu keuntungan utama dari MFC adalah kemampuannya untuk mengolah limbah sambil menghasilkan energi. Dengan menggunakan limbah organik sebagai sumber bahan bakar, MFC dapat mengurangi polusi dan emisi gas rumah kaca. Selain itu, teknologi ini dapat diterapkan di berbagai sektor seperti pengolahan air limbah dan produksi bioenergi.
Tantangan Peluang
Tantangan dan Peluang Pengembangan
Meskipun memiliki potensi besar, MFC masih menghadapi beberapa tantangan seperti efisiensi konversi energi yang rendah dan biaya produksi yang tinggi. Namun, penelitian terus dilakukan untuk meningkatkan kinerja dan menurunkan biaya teknologi ini. Dengan perkembangan lebih lanjut, MFC berpotensi menjadi bagian integral dari sistem energi hijau di masa depan.
Aplikasi Praktis
Aplikasi Praktis Sel Bahan Bakar Mikroba
Saat ini, aplikasi praktis dari MFC meliputi pengolahan air limbah industri dan domestik serta penyediaan listrik di daerah terpencil. Teknologi ini juga sedang dieksplorasi untuk digunakan dalam perangkat portabel kecil seperti sensor lingkungan. Dengan terus berkembangnya penelitian di bidang ini, kemungkinan aplikasi baru akan terus muncul seiring waktu.